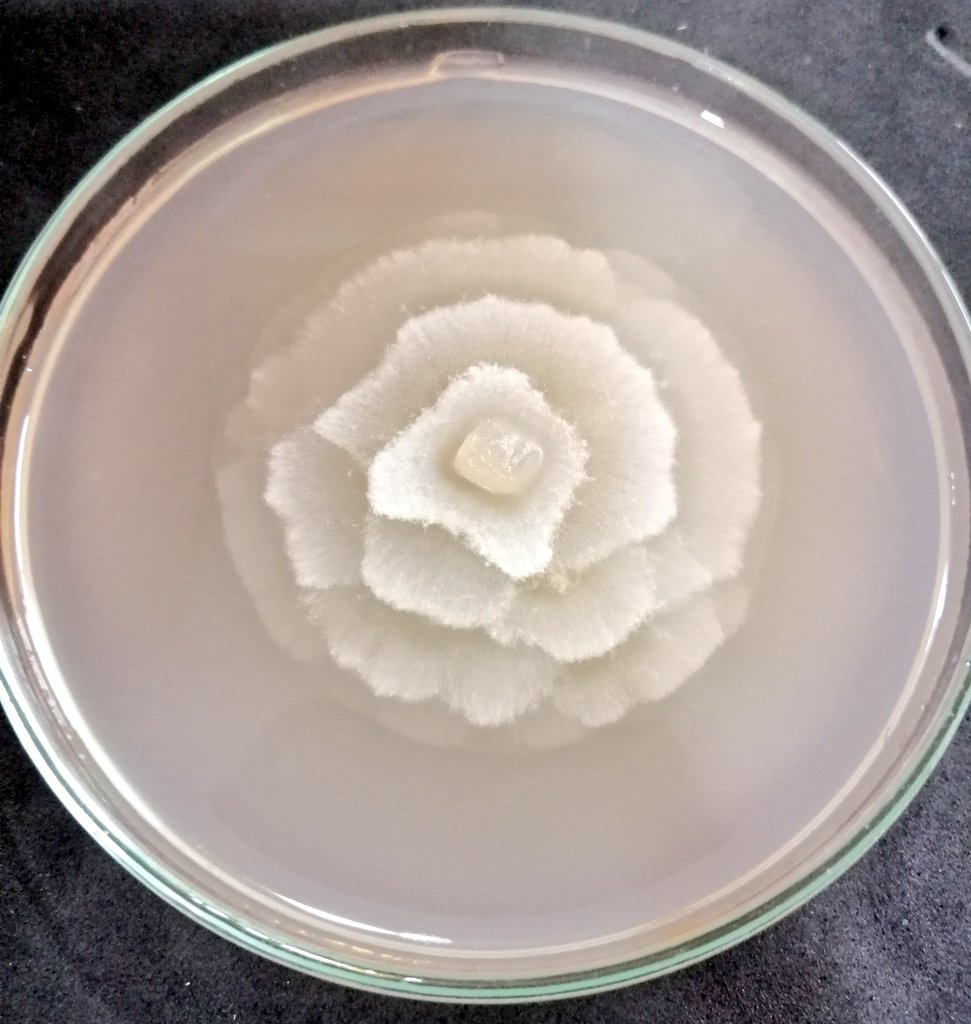
Cada vez más enamorada de lo que hago 🤩🤩🤩 #PlantPathology

Şener Kurt
@enerkurt1
ID: 464509793
15-01-2012 09:26:18
54 Tweet
77 Followers
505 Following





Lead by Prof. G. H. Goldman from São Paulo Fungal Group, Frontiers #Fungal #Biology aims to publish significant research findings on all aspects of fungal biology to enhance our ability to decipher the nature of the complex interactions of #fungi. Journal's scope: fro.ntiers.in/FungalBiol



Sevgili babamı dün kaybettik. Bu zor günümüzde, yüzlerce taziye mesajı beni çok duygulandırdı. Herkese şükranlarımı iletirim🙏. Babam 1962 İstanbul tıp fakültesi mezunuydu. Doktorların çok az olduğu devirde, Anadolu’nun her yerinde, 40 yıl tamamen kendi isteği ile hekimlik yaptı.



#Fusarium spp. found in #potato in Algeria 🥔🥔🥔 Just published, congratulations Nadia Azil ! rdcu.be/cdctC


Ülkemizin İLK ve TEK 🍃Bitki Sağlığı Kliniği Uygulama ve Araştırma Merkezi🌿olan DOĞAKA destekli bitki hastanesiyle; tarladan sofraya uzanan üretim zinciri içinde temiz ve sağlıklı gıdaya erişim desteklenmektedir. 🎬Türkçe📽: youtube.com/watch?v=h6rPtj… Sanayi ve Teknoloji Bakanlığı Kalkınma Ajansları Genel Müdürlüğü